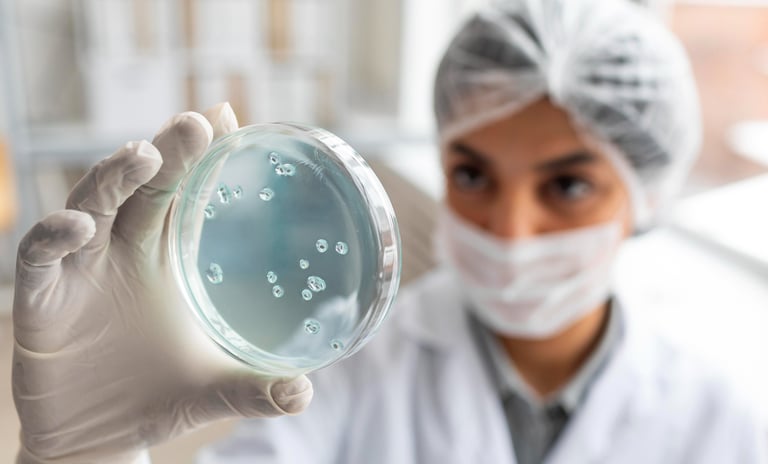
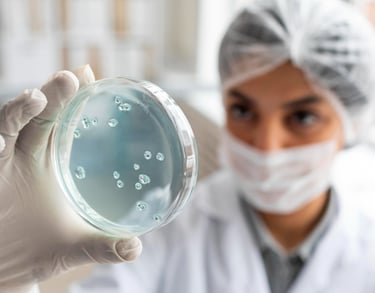
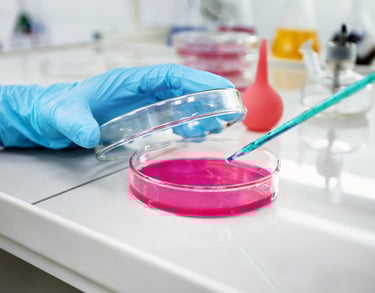
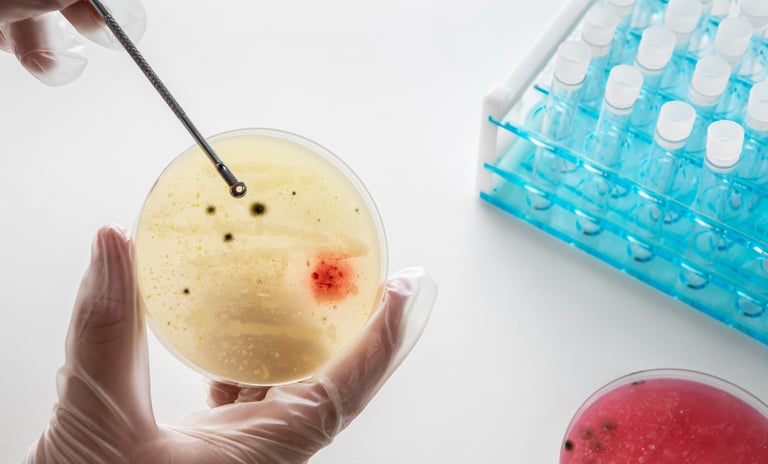

Nos Analyses
Nous réalisons des analyses biologiques complètes avec des équipements modernes afin de garantir des résultats fiables, rapides et sécurisés pour votre suivi médical.
HEMATOLOGIE
Étude complète des cellules sanguines : globules rouges, globules blancs et plaquettes.Permet de dépister l’anémie, les infections, les inflammations ou les troubles de la coagulation


BIOCHIMIE
Analyses permettant d’évaluer le fonctionnement des organes (foie, reins, cœur), le taux de sucre, de cholestérol, les enzymes et les électrolytes.Indispensable pour un bilan de santé complet


ALLERGOLOGIE
Tests sanguins pour identifier les allergies alimentaires, respiratoires, médicamenteuses ou cutanées. Une analyse précise pour comprendre vos réactions allergiques.


Pour toute information ou prise de rendez-vous, contactez-nous dès maintenant.
IMMUNOLOGIE
Étude du système immunitaire pour détecter les infections, maladies autoimmunes, déficits immunitaires et anomalies inflammatoires Analyses essentielles pour un diagnostic fiable.

MYCOLOGIE
Recherches de champignons et levures responsables d’infections cutanées, vaginales ou digestives. Permet un traitement ciblé et efficace.


BIOLOGIE MOLECULAIRE
Détection génétique très précise de virus, bactéries ou mutations grâce aux techniques PCR.Méthode rapide et hautement fiable pour un diagnostic pointu.


Besoin d’informations supplémentaires ou d’un rendez-vous ? Nous sommes à votre écoute.
PARASITOLOGIE
Recherche de parasites dans les selles, le sang ou autres prélèvements.Utile pour diagnostiquer les infestations parasitaires et orienter le traitement adéquat.

BACTERIOLEGIE
Bactériologie : Identification des bactéries responsables d’infections (gorge, urines, peau, infections génitales…).Comprend également l’antibiogramme pour guider le choix du traitement.

HORMONOLOGIE
Hormonologie : Dosage des hormones thyroïdiennes, sexuelles, de fertilité, du stress et du métabolisme. Permet d’évaluer l’équilibre hormonal et de comprendre de nombreux symptômes.


BIOLOGIE DE LA REPRODUCTION
Analyse des liquides séminaux et des spermatozoïdes (spermogramme) pour évaluer la fertilité masculine.


